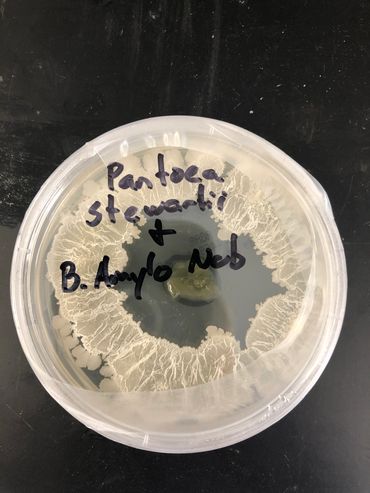
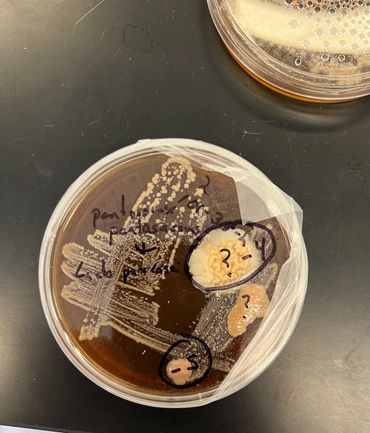
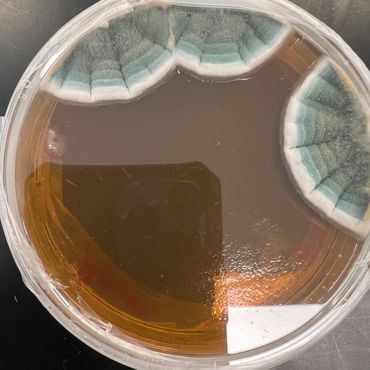

Discover Natures Probiotics

At Cereus Biotechnology, our mission is to discover and apply natural and sustainable probiotic solutions to plant and animal health.

Our team consists of experienced scientists and specialists who are passionate about regenerative agriculture and dedicated to achieving our mission.

We discover unique plant probiotic micro organisms and manufacture at economies of scale that are cost effective for farmers. Batch record control using good laboratory practices insure reproducible high quality products.
Cereus Microbe Interview with Founder Rob Tengler and Teresa Armijo

At Cereus Biotechnology, we improve the lives of people around the world through the development of natures brilliant solutions.
Live concentrate treats up to 8000 square feet per gallon

Universal plant bio-stimulant enhancing nutrient uptake, and plant growth promoting metabolites (amino acids, enzymes, and organic acids). Improves overall plant vigor and pathogen protection under stress conditions.

Fruit and vegetable preservation with pathogen protection. Helps maintain the shelf-life and nutrient value of produce and other cash crops through competitive inhibition and secondary metabolites.

Sustainable fungal and mildew control using microbes to combat disease states in flowering plants, fruits, vegetables, trees and wood products.

A combination of Plant Growth Promoting Rhyzobacteria (PGPR) to enhance disease resistance, stimulate plant sub-soil root growth and above-soil fruit and biomass production.

Microbial broths from our 'Live Active Cultures' contains organic acids which lower pH values within alkaline soils and improves nutrient uptake for plant growth without increasing osmotic stress.

A combination of universal growth promoting microorganisms plus nitrogen fixing microbes which extract nitrogen (N2) from the atmosphere and make this vital element available for plant growth.

These microbes repair damaged soils, remove toxins and oils (by breaking down long chain hydrocarbons and pesticides) to improve growth conditions for plants, grasses and food crops.

The ultimate plant probiotic to stimulate root and shoot growth. This proprietary blend of growth promoting organisms supercharges plant vigor for maximum productivity.

Water clarifying microbes flocculates particulates and removes tannins which results in improved water clarity and lower pH values.
BioChar to Capture both Carbon and Beneficial Micro organisms

All of our best plant probiotics on solid carbon support

Nitrogen fixing microbes on carbon support for long term plant health

Allows plants to thrive with added protection against fungus
BioChar Products are sold in Cubic Yard Quantities

We use the latest techniques and technologies to develop regional treatments for plants based on their unique growth challenges. This approach leads to applications that have greater efficacy.
BioChar from Wakefiield Farms provides a high porosity inert carbon scaffold for our micro organisms while locking carbon from re-entering the carbon cycle, and providing a carbon negative sink.
Traditional nitrogen fertilizers are energy intensive, expensive and are often over applied. Nitrogen in the air is abundant but not useable for plants until its converted into useable forms via microbial nitrogen fixation. By utilizing Cereus bio machinery to capture nitrogen farmers can save costs and decrease pollution.
Probiotic plant micro organisms are often referred to as bio-catalysis. This means that they are not used up, but instead continue to provide benefits over months and even years from initial application. Cereus soil microbes have been proven to remain viable from season to season in the soil, thus providing long term improvement to soil health.
Our protective class of organisms are selected to favor healthy plant growth when non-ideal conditions favor pathogens. High moisture, damaged crops, or stressed plants are more susceptible to disease states.
Our team of innovative scientists are always curious and willing to help develop products for your unique application. We welcome opportunities to collaborate.
We love our customers, so feel free to visit during normal business hours.
21 East 2nd Avenue, Longmont, Colorado 80501, United States
Open today | 09:00 am – 05:00 pm |
Sign up to hear from us.